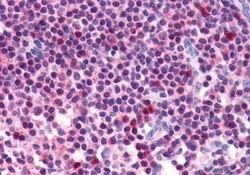
Invitrogen FZD5 Polyclonal Antibody 50 &mu;g; Unconjugated:Antibodies,

missing translation for 'onlineSavingsMsg'
Learn More
Learn More
Invitrogen™ FZD5 Polyclonal Antibody


Rabbit Polyclonal Antibody
Brand: Invitrogen™ PA533557
This item is not returnable.
View return policy
Description
Percent identity with other species by BLAST analysis: Human, Gorilla, Gibbon, Mouse, Rat, Hamster, Elephant (100%) Dog, Rabbit (94%).
Members of the 'frizzled' gene family encode 7-transmembrane domain proteins that are receptors for Wnt signaling proteins. The FZD5 protein is believed to be the receptor for the Wnt5A ligand.
Specifications
| FZD5 | |
| Polyclonal | |
| Unconjugated | |
| FZD5 | |
| C2orf31; DKFZp434E2135; frizzled 5, seven transmembrane spanning receptor; frizzled class receptor 5; frizzled family receptor 5; frizzled-5; Fz5; Fz-5; Fzd5; Fzd-5; FzE5; HFZ5; MGC129692; seven-transmembrane receptor frizzled-5; Wnt receptor | |
| Rabbit | |
| Antigen affinity chromatography | |
| RUO | |
| 100762351, 14367, 317674, 7855 | |
| Store at 4°C short term. For long term storage, store at -20°C, avoiding freeze/thaw cycles. | |
| Liquid |
| Immunohistochemistry (Paraffin) | |
| 1 mg/mL | |
| PBS with 0.1% sodium azide | |
| Q13467, Q8CHL0, Q9EQD0 | |
| FZD5 | |
| Synthetic 16 amino acid peptide from N-terminal extracellular domain of human FZD5 / Frizzled 5. | |
| 50 μg | |
| Primary | |
| Human, Mouse, Rat, Hamster | |
| Antibody | |
| IgG |
Product Content Correction
Your input is important to us. Please complete this form to provide feedback related to the content on this product.
Product Title
Spot an opportunity for improvement?Share a Content Correction